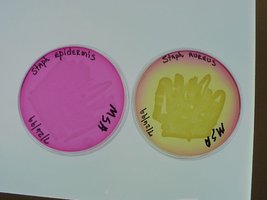
MSA plates: S. epidermidis (red, no fermentation) and S. aureus (yellow, fermentation)
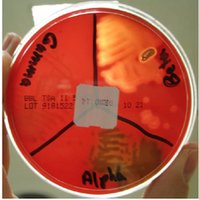
Blood agar plate divided into sections for alpha, beta, and gamma hemolysis

BackIsolation and Identification of Staphylococcus and Streptococcus
Study Guide - Smart Notes
Tailored notes based on your materials, expanded with key definitions, examples, and context.
Staphylococcus
General Characteristics
Staphylococci are Gram-positive cocci that are catalase positive and halophilic. They are commonly found on the skin and mucous membranes and are responsible for a variety of infections, including abscesses, boils, septicemia, endocarditis, cystitis, osteomyelitis, and pyelonephritis. The most clinically significant species include Staphylococcus aureus, S. epidermidis, and S. saprophyticus.
S. aureus: Most virulent; can survive for months on dry surfaces; spread by contact with pus, skin, or objects; MRSA is resistant to most β-lactam antibiotics.
S. epidermidis: Normal skin flora; not usually pathogenic; major virulence factor is biofilm formation, especially on catheters; sensitive to novobiocin.
S. saprophyticus: Normal flora of female genitalia; causes community-acquired urinary tract infections; resistant to novobiocin.
Isolation and Identification of Staphylococci
Selective and differential media are used to isolate and identify Staphylococci. Mannitol Salt Agar (MSA) is commonly used for this purpose.
Selective agent: 7.5% sodium chloride inhibits most bacteria except Staphylococci.
Differential agent: Mannitol fermentation is detected by phenol red pH indicator.
Interpretation: S. aureus ferments mannitol, producing acid and turning the medium yellow. Other species, such as S. epidermidis, do not ferment mannitol, so the medium remains red.
Coagulase Test
The coagulase test is the definitive method for confirming the pathogenicity of S. aureus. This test detects the ability of the organism to clot plasma, which is a characteristic of nearly all pathogenic S. aureus strains. Other Staphylococci are coagulase negative.
Inoculate plasma with the test organism and incubate at 37°C for several hours.
Any clot formation is a positive result, indicating S. aureus.

Streptococcus
General Characteristics
Streptococci are Gram-positive cocci that are catalase negative and usually found in chains. They are facultatively anaerobic and can be found in humans and animals, as well as in non-animal environments. Pathogenic species include Streptococcus pneumoniae and S. pyogenes.
Commonly colonize mucosal surfaces of the mouth, nares, and pharynx.
Cause diseases such as septic sore throat, pneumonia, erysipelas, endocarditis, and meningitis.
Hemolysis on Blood Agar Plates (BAP)
Streptococci are classified based on their hemolytic properties on blood agar:
Alpha (α) hemolysis: Partial lysis of RBCs, greenish-brown color (e.g., S. pneumoniae).
Beta (β) hemolysis: Complete lysis of RBCs, clear zone (e.g., S. pyogenes).
Gamma (γ) hemolysis: No hemolysis, RBCs remain intact.
Identification of Streptococci Using Blood Agar and Disks
Blood agar plates (BAP) are used to culture Streptococci and observe hemolysis. Disks containing specific chemicals are used for further identification:
P disk (optochin): Inhibits S. pneumoniae but not other alpha-hemolytic Streptococci.
A disk (bacitracin): Inhibits Group A beta-hemolytic Streptococci (S. pyogenes).

Special Culturing Conditions
Streptococci from the upper respiratory tract are often isolated using a capnophilic environment (high CO2), such as a Brewer's jar.

Lancefield Grouping
Beta-hemolytic Streptococci are further classified by Lancefield grouping, based on cell wall antigens:
Group A: Most virulent, includes S. pyogenes, sensitive to bacitracin.
Group B: Insensitive to bacitracin.
Rapid Strep tests detect Group A antigen for quick diagnosis of Streptococcal sore throat, but positive results should be confirmed by culturing on BAP.
Summary Table: Hemolysis and Identification of Streptococci
Hemolysis Type | Appearance on BAP | Example Species | Disk Sensitivity |
|---|---|---|---|
Alpha (α) | Greenish-brown, partial lysis | S. pneumoniae | Optochin (P) sensitive |
Beta (β) | Clear, complete lysis | S. pyogenes | Bacitracin (A) sensitive (Group A) |
Gamma (γ) | No change, no lysis | Non-pathogenic Streptococci | Not applicable |
Key Definitions
Catalase Test: Differentiates Staphylococci (catalase positive) from Streptococci (catalase negative).
Coagulase Test: Identifies pathogenic S. aureus (coagulase positive).
Mannitol Salt Agar (MSA): Selective and differential medium for Staphylococci.
Blood Agar Plate (BAP): Used to observe hemolysis by Streptococci.
Lancefield Grouping: Serological classification of beta-hemolytic Streptococci based on cell wall antigens.
Additional info: The use of selective and differential media, as well as biochemical tests, is essential for the accurate identification of clinically significant Staphylococcus and Streptococcus species. Understanding hemolytic patterns and antibiotic sensitivities aids in diagnosis and treatment decisions.